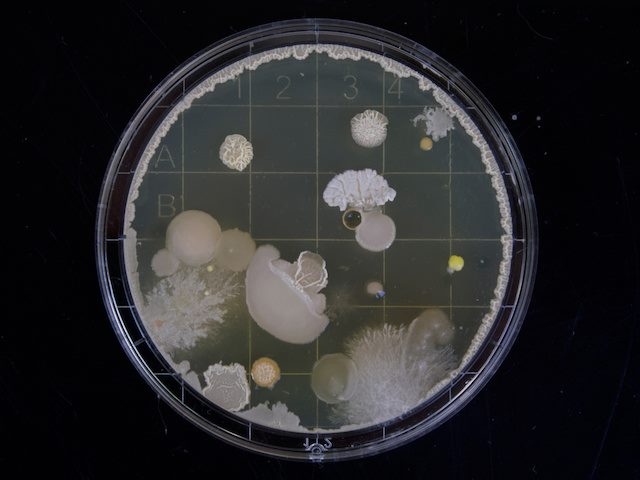

Successful data-driven marketing campaigns rely on two components: 1) a thoughtful strategic campaign and 2) a customer valuation model to predict and then judge the impact of the campaign actions.
After looking at customer valuations, and more broadly asset valuation, in numerous industries over more years than I care to claim, a few key factors persistently have the most impact on model success.
Follow the Cash Flows
Conceptually, customer valuation is very simple. Take all the expected future cash flows in and out of the organization for a customer, discount them to today, add them together. Done!
The tricky part comes when working out what changes are needed to your data to support this effort, how you meaningfully group the cashflows together, how far in the future is it reasonable to look, and in what ways you should segment the customers to leverage the result.
Related Article: The Future of Customer Experience Lies in Segmentation
Accounting Data Isn't Enough
Most organizations invest heavily in great accounting data. So it can come as a shock to finance and marketing executives sponsoring a valuations project to learn that the very expensive data is not sufficient.
Accounting data aggregates information in a manner necessary to support accounting. This aggregation is often at an enterprise or group level rather than the detailed level required for an effective customer valuation model. A particular challenge is often organizing the data to be able to look at changes through time rather than at a specific point in time (something at which accounting data excels).
What Data Do You Need?
Gathering the right data is critical to success. The challenge is to not go too deep. Building models with over 10,000 cash flow line items is highly intractable. The right level tends to be groupings which can be impacted by marketing or other actions. As they are impactable and representative of customer behavior, many organizations call these groupings “drivers.”
For example, in the credit card space, losses are a meaningful measure that can be impacted by increasing or decreasing the risk profile of new customers.
In my experience, the point of diminishing returns — whether from a meaningful ability to impact or just an ability to grok the business — caps out at around 20 drivers.
Related Article: Your Data-Driven Marketing Fitness Regime
The Art of Terminal Values
You nailed the data. It’s organized in ways that provide levers to your marketing campaign. And then you realize more than 50 percent of customer value is occurring more than five years in the future, a period that is often lumped together under the umbrella “terminal value.” What happened? And is this reasonable?
Low interest rates mean that distant future cash flows are almost equal to cash flows next quarter. The low interest rates we have enjoyed in recent years have been a boon to housing prices, the stock market, and of course, your customer value.
Is this reasonable? This is where the artistic side of data science comes to the fore. How stable is your industry? What would be the impact of external events? Is the length of your data particularly long or short? How does the terminal value change as a result of changes in your underlying drivers? Is it particularly sensitive to a particular driver? These are all questions a strong group of analysts will ask and seek to answer.
Related Article: 4 Keys to Improving Your Analytics Team
Fold In Customer Data Segments
Earlier we grouped cash flows by type and potential marketing action impact. Another dimension can be added to this mix: data about our customers. This data allows us to group similar customers together so that we can identify more (or less) profitable ones, as well as identify the actions most likely to provide positive benefit to the customer.
From a customer valuation perspective, the most valuable segmentation data splits customers into highly differentiated groups, whether by profitability or behavior. For example, two groups can have nearly identical value but achieve it in very different ways, such as a single high dollar purchase group compared to a many small purchases group.
For more on customer segmentation please see my past article, "8 Ways to Segment Your Customer Data."
Blending Hard Science and Artistry
Customer valuations are a critical part of modern marketing campaigns. They provide the feedback mechanism that has accelerated the impact of digital marketing in the modern era.
These models rely on both the expected hard science of data and statistics, but also, as we see with terminal valuations, require the data scientist to take a pragmatic, thoughtful, and yes, artistic view of the customer.
Learn how you can join our contributor community.